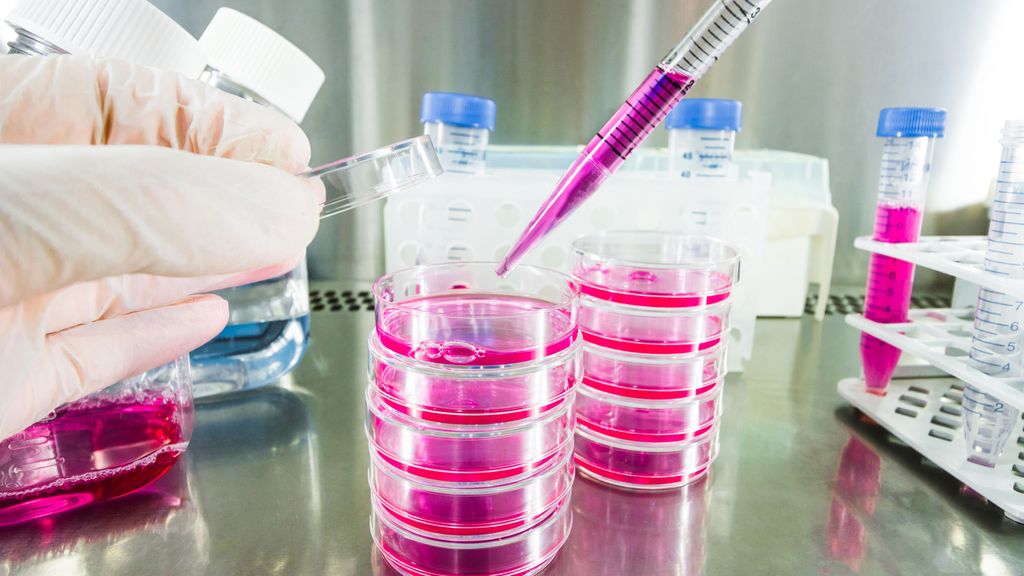

©
Getty Images/iStockphoto
Interview mit PD Dr. med. Antonia Maria Müller
Leading Opinions Digital
30
Min. Lesezeit
30.11.2018
Weiterempfehlen
<p class="article-intro">Dr. Müller berichtet im Gespräch über die aktuellen Studiendaten zur Stammzelltransplantation.</p>
<hr />
<p class="article-content"><p><iframe src="https://player.vimeo.com/video/304556997" width="640" height="360" frameborder="0" allowfullscreen="allowfullscreen"></iframe></p></p>
Das könnte Sie auch interessieren:
Erhaltungstherapie mit Atezolizumab nach adjuvanter Chemotherapie
Die zusätzliche adjuvante Gabe von Atezolizumab nach kompletter Resektion und adjuvanter Chemotherapie führte in der IMpower010-Studie zu einem signifikant verlängerten krankheitsfreien ...
Highlights zu Lymphomen
Assoc.Prof. Dr. Thomas Melchardt, PhD zu diesjährigen Highlights des ASCO und EHA im Bereich der Lymphome, darunter die Ergebnisse der Studien SHINE und ECHELON-1
Aktualisierte Ergebnisse für Blinatumomab bei neu diagnostizierten Patienten
Die Ergebnisse der D-ALBA-Studie bestätigen die Chemotherapie-freie Induktions- und Konsolidierungsstrategie bei erwachsenen Patienten mit Ph+ ALL. Mit einer 3-jährigen ...


